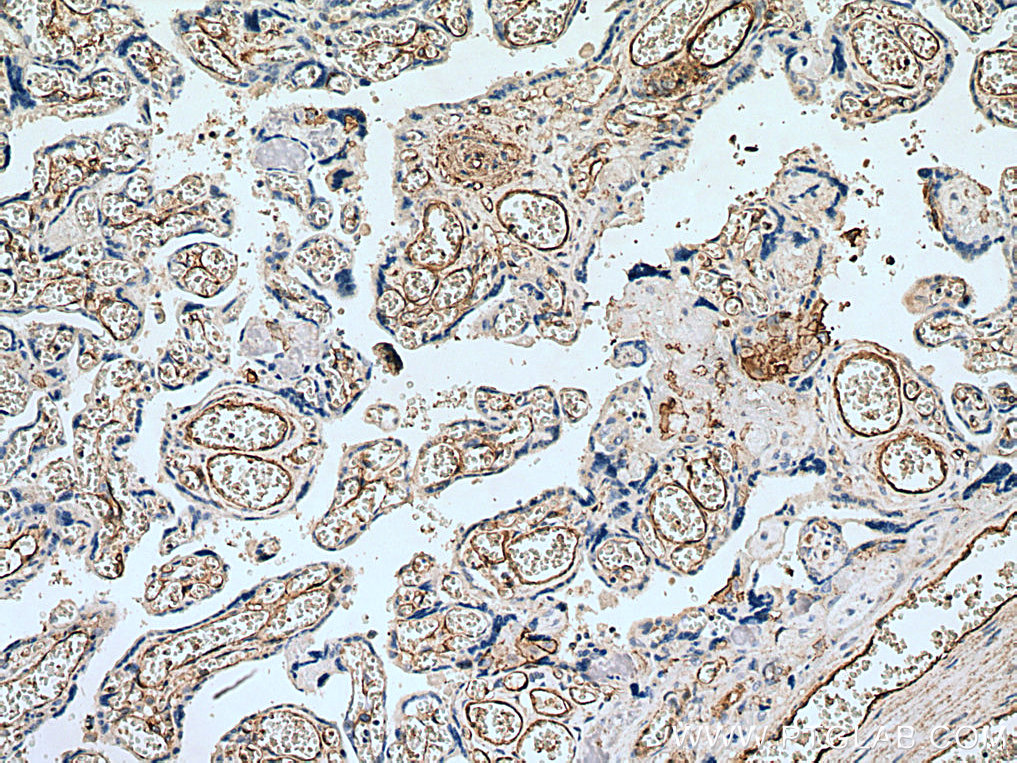

验证数据展示
经过测试的应用
| Positive WB detected in | HepG2 cells, HeLa cells, A375 cells, L02 cells, HUVEC cells, human placenta tissue |
| Positive IHC detected in | human liver cancer tissue, human placenta tissue, human rectal cancer tissue Note: suggested antigen retrieval with TE buffer pH 9.0; (*) Alternatively, antigen retrieval may be performed with citrate buffer pH 6.0 |
| Positive IF-P detected in | human liver cancer tissue, human placenta tissue |
| Positive IF/ICC detected in | HUVEC cells |
推荐稀释比
| 应用 | 推荐稀释比 |
|---|---|
| Western Blot (WB) | WB : 1:2000-1:20000 |
| Immunohistochemistry (IHC) | IHC : 1:1000-1:4000 |
| Immunofluorescence (IF)-P | IF-P : 1:1000-1:4000 |
| Immunofluorescence (IF)/ICC | IF/ICC : 1:250-1:1000 |
| It is recommended that this reagent should be titrated in each testing system to obtain optimal results. | |
| Sample-dependent, Check data in validation data gallery. | |
产品信息
66153-1-Ig targets CD146/MCAM in WB, IHC, IF/ICC, IF-P, ELISA applications and shows reactivity with human samples.
| 经测试应用 | WB, IHC, IF/ICC, IF-P, ELISA Application Description |
| 文献引用应用 | WB, IHC |
| 经测试反应性 | human |
| 文献引用反应性 | human |
| 免疫原 |
CatNo: Ag11855 Product name: Recombinant human CD146, MCAM protein Source: e coli.-derived, PET28a Tag: 6*His Domain: 26-350 aa of BC056418 Sequence: GEAEQPAPELVEVEVGSTALLKCGLSQSQGNLSHVDWFSVHKEKRTLIFRVRQGQGQSEPGEYEQRLSLQDRGATLALTQVTPQDERIFLCQGKRPRSQEYRIQLRVYKAPEEPNIQVNPLGIPVNSKEPEEVATCVGRNGYPIPQVIWYKNGRPLKEEKNRVHIQSSQTVESSGLYTLQSILKAQLVKEDKDAQFYCELNYRLPSGNHMKESREVTVPVFYPTEKVWLEVEPVGMLKEGDRVEIRCLADGNPPPHFSISKQNPSTREAEEETTNDNGVLVLEPARKEHSGRYECQGLDLDTMISLLSEPQELLVNYVSDVRVSP 种属同源性预测 |
| 宿主/亚型 | Mouse / IgG1 |
| 抗体类别 | Monoclonal |
| 产品类型 | Antibody |
| 全称 | melanoma cell adhesion molecule |
| 别名 | CD146, 4D8A9, MUC18, Melanoma-associated antigen MUC18, Melanoma-associated antigen A32 |
| 计算分子量 | 646 aa, 72 kDa |
| 观测分子量 | 120 kDa |
| GenBank蛋白编号 | BC056418 |
| 基因名称 | CD146 |
| Gene ID (NCBI) | 4162 |
| RRID | AB_2881549 |
| 偶联类型 | Unconjugated |
| 形式 | Liquid |
| 纯化方式 | Protein G purification |
| UNIPROT ID | P43121 |
| 储存缓冲液 | PBS with 0.02% sodium azide and 50% glycerol, pH 7.3. |
| 储存条件 | Store at -20°C. Stable for one year after shipment. Aliquoting is unnecessary for -20oC storage. |
背景介绍
CD146, also known as melanoma cell adhesion molecule (MCAM) or MUC18, originally identified as a biomarker of melanoma progression, is a transmembrane glycoprotein of 113-130 kDa, belonging to the immunoglobulin (Ig) superfamily (PMID: 8378324; 25993332). Structurally, it consists of five Ig domains, a transmembrane domain, and a cytoplasmic region. In normal adult tissue, CD146 is primarily expressed by vascular endothelium and smooth muscle. CD146 is a key cell adhesion protein in vascular endothelial cell activity and angiogenesis, and has been used as marker of circulating endothelium cells (CECs) (PMID: 19356677). In addition to the membrane-anchored form of CD146, a soluble form of CD146 (sCD146, 105 kDa) has also been found in human plasma and in the supernatant of cultured human endothelial cells (PMID: 9462829; 19229070; 16374253; 14597988). This antibody detects a band at approximately 120 kDa that corresponds to the molecular weight of glycosylated CD146. Treatment of lysates of HepG2 cells and L02 cells with PNGase F, which removes oligosaccharides from N-linked glycoproteins, led to a down-shift of the detected band.
实验方案
| Product Specific Protocols | |
|---|---|
| IF protocol for CD146/MCAM antibody 66153-1-Ig | Download protocol |
| IHC protocol for CD146/MCAM antibody 66153-1-Ig | Download protocol |
| WB protocol for CD146/MCAM antibody 66153-1-Ig | Download protocol |
| Standard Protocols | |
|---|---|
| Click here to view our Standard Protocols |
发表文章
| Species | Application | Title |
|---|---|---|
Exp Cell Res Nrf2 activation is involved in osteogenic differentiation of periodontal ligament stem cells under cyclic mechanical stretch. | ||
Cell Signal Glioma-derived small extracellular vesicles induce pericyte-phenotype transition of glioma stem cells under hypoxic conditions | ||
Ultrastruct Pathol Immunohistochemical and ultrastructural identification of telocytes in the infantile hemangioma |